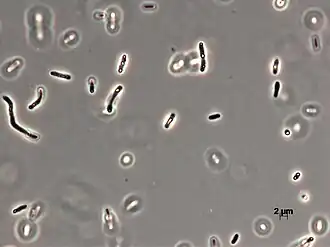

Aquabacterium
| Aquabacterium | ||||||||||||
|---|---|---|---|---|---|---|---|---|---|---|---|---|
Aquabacterium limnoticum | ||||||||||||
| Systematik | ||||||||||||
| ||||||||||||
| Wissenschaftlicher Name | ||||||||||||
| Aquabacterium | ||||||||||||
| Kalmbach et al. 1999[1] |
Aquabacterium ist eine Gattung beweglicher, stäbchenförmiger, gramnegativer, Oxidase-positiver und Katalase-negative Bakterien aus der Ordnung Burkholderiales, die 1999 aus Biofilmen der Berliner Trinkwasser-Versorgung isoliert wurden.[2][1] Zu den damals identifizierten Arten gehören Aquabacterium citratiphilum, Aquabacterium parvum und Aquabacterium commune. Diese Arten werden repräsentiert durch drei aus Biofilmen des Berliner Trinkwassersystems isolierte Bakterienstämme, die im Hinblick auf ihre morphologischen und physiologischen Eigenschaften und ihre taxonomische Stellung charakterisiert wurden.[1]
Die Typusart der Gattung ist Aquabacterium commune.[2]
Beschreibung
Vom Phänotyp handelte es sich bei den 1999 gefundenen und untersuchten Bakterien um bewegliche, gramnegative Stäbchen, die eine Oxidase, aber keine Katalase besitzen und als Speicherpolymere Polyalkanoate (alias Polyhydroxyalkanoate[3][4]) und Polyphosphat enthielten. Sie zeigten ein mikroaerophiles Wachstumsverhalten und nutzten Sauerstoff und Nitrat als Elektronenakzeptoren, nicht aber Nitrit, Chlorat, Sulfat oder Eisen(III). Zu den verstoffwechselten Substraten gehört ein breites Spektrum an organischen Säuren, aber keine Kohlenhydrate. Die drei 1999 in Berlin gefundenen Arten lassen sich anhand ihrer Substratnutzung, ihrer Fähigkeit zur Hydrolyse von Harnstoff und Kasein, ihrer zellulären Proteinmuster, ihres Wachstums auf nährstoffreichen Medien sowie ihrer Temperatur-, pH- und NaCl-Toleranz voneinander unterscheiden.[1]
Die Zellen der drei 1999 in Berlin gefundenen Arten sind i. A. aufgrund polarer (endständiger) Geißeln beweglich (motil). Sie sind mesophil (mittlere Temperaturbereiche bevorzugend), lediglich die Art Aquabacterium tepidiphilum ist leicht thermophil (wärmeliebend).[1]
Habitat
Die drei ursprünglichen Spezies (Arten) A. citratiphilum, A. parvum und A. commune wurden aus Biofilmen in Trinkwasserinstallationen isoliert. Vertreter der Gattung können aber auch in Süßwasserquellen und Böden gefunden werden,[1] möglicherweise auch im Darm von Hühnerkücken (siehe §Artenliste).
Etymologie
Der Gattungsname leitet sich ab von lateinisch aqua ‚Wasser‘ und verweist damit auf das Berliner Trinkwassersystem als Fundort der drei ursprünglichen Arten (inklusive der Typusart) im Jahr 1999.[1]
Systematik
Eine phylogenetische Analyse durch Sibylle Kalmbach et al. auf der Grundlage eines 16S-rRNA-Gen-Sequenzvergleichs ergab 1999, dass die Berliner Isolate B4, B6 und B8 der Familie Comamonadaceae (früher als „Beta-1-Untergruppe“ oder „-klasse“ bezeichnet[5]) des Phylums Pseudomonadota (Proteobakterien) angehören. Diese drei ursprünglichen Isolate bilden jeweils eine eigene Arten (Spezies), sie haben mit einem internen Verwandtschaftsgrad der DNA von 44,9 bis 51,3 %. Daher wurde 1999 vorgeschlagen, eine neue Gattung Aquabacterium zu schaffen, mit den Spezies A. citratiphilum, A. parvum und A. commune und diesen drei Isolaten als jeweiligem Referenzstamm. Die Typusart der neuen Gattung ist A. commune.[1]
Die Familienzugehörigkeit ist in der Taxonomie des National Center for Biotechnology Information (NCBI) abweichend als incertae sedis (innerhalb der Ordnung Burkholderiales) angegeben,[6] in der Genome Taxonomy Database (GTDB) als Burkholderiaceae_B.[7][A. 1]
Artenliste
Die folgende Liste umfasst die Arten der Gattung Aquabacterium nach der List of Prokaryotic names with Standing in Nomenclature (LPSN)[2] mit Ergänzungen (insbes. Referenzstämme) gemäß der Taxonomie des NCBI.[6] Ein hochgestelltes G in Klammern verweist auf die GTDB[7] – Stand: 2. Januar 2024:
Gattung Aquabacterium Kalmbach et al. 1999(G)
- Aquabacterium citratiphilum Kalmbach et al. 1999
- Referenzstamm: B4 alias ATCC:BAA-207, CIP:106985 oder DSM:11900 – Fundort: Berlin, im Trinkwassersystem
- Aquabacterium commune Kalmbach et al. 1999(G) (Typus)(G)
- Referenzstamm: B8 alias ATCC:BAA-209, CCUG:48318, CIP:106984 oder DSM:11901 – Fundort: Berlin, im Trinkwassersystem
- „Candidatus Aquabacterium excrementipullorum“ Gilroy et al. 2021(G)
- Referenzstamm: ChiHile3-4534 – Fundort: Mikrobiom im Darm von Hühnern/Hühnerkücken
- Aquabacterium fontiphilum Lin et al. 2009(G)
- Referenzstamm: CS-6 alias BCRC:17729 oder BCCM/LMG:24215 – Fundort: Taiwan, im Wasser
- „Aquabacterium hongkongensis“ T. Zhang et al. 2006 – nur NCBI
- Referenzstamm: CA5 (≠ Mesorhizobium sp. CA5) – Fundort: Hongkong, im Trinkwassersystem
- Aquabacterium lacunae Chen et al. 2020(G) [inkl. Aquabacterium sp. KMB7]
- Referenzstamm: KMB7 alias BCRC:81156, BCCM/LMG:30924 oder KCTC:62867 – Fundort: Taiwan, im Wasser
- Aquabacterium limnoticum Chen et al. 2012[9]
- Referenzstamm: ABP-4 alias BCRC:80167 oder KCTC:23306 – Fundort: Taiwan, im Boden einer Süßwasserquelle
- Aquabacterium olei Pham et al. 2015(G) [inkl. Aquabacterium sp. NHI-1]
- Referenzstamm: NHI-1 alias KEMC:9005-082, KACC:18244 oder NBRC:110486 – Fundort: Südkorea, in ölkontaminiertem Boden
- Aquabacterium parvum Kalmbach et al. 1999(G)
- Referenzstamm: B6 alias ATCC:BAA-208, CCUG:48317, CIP:106983 oder DSM:11968 – Fundort: Berlin, im Trinkwassersystem
- Aquabacterium soli Sun et al. 2021(G) [inkl. Aquabacterium sp. SJQ9]
- Referenzstamm: SJQ9 alias CCTCC:AB 2018284 oder JCM:33106 – Fundort: Shanghai, im Boden
- Aquabacterium terrae Dahal et al. 2021 [inkl. Aquincola sp. S2]
- Referenzstamm: S2 alias KCTC:72741 oder NBRC:114609 – Fundort: Seoul, im Boden
- Aquabacterium sp. NJ1[10] [Aquabacterium sp000768065(G)] – nicht LPSN
- Referenzstamm: NJ1 – Fundort: New Jersey, im Boden
Verschiebungen nach LPSN[6] und GTDB:[7]
- Aquabacterium pictum Hirose et al. 2020 → Rubrivivax pictus (Hirose et al. 2020) Liu et al. 2023 [Aquabacterium_A pictum(G)]
- Aquabacterium tepidiphilum Khan et al. 2019 → Caldimonas tepidiphila (Khan et al. 2019) Liu et al. 2023 [Aquabacterium_B tepidiphilum(G)]
Anmerkungen
- ↑ Die GTDB führt die Gattung Aquabacterium (nebst einigen Abspaltungen) in einer Familie mit der provisorischen Bezeichnung Burkholderiaceae_B. Ein Vergleich dieser GTDB-Familie mit dem phylogenetischen Baum bei Ling et al. (2015), Extended Data Fig. 2, legt aber nahe, dass „Aquabakterien“ bzw. "Aquabacteria" und Burkholderiaceae_B dieselbe Klade bezeichnen;[8] siehe auch „Eleftheria terrae“. Vom Umfang her stimmen Burkholderiaceae_B (GTDB) und Comamonadaceae (LPSN) weitestgehend überein, scheinen also auch synonym zu sein.
Einzelnachweise
- ↑ a b c d e f g h Sibylle Kalmbach, Werner Manz, Jörg Wecke, Ulrich Szewzyk: Aquabacterium gen. nov., with description of Aquabacterium citratiphilum sp. nov., Aquabacterium parvum sp. nov. and Aquabacterium commune sp. nov., three in situ dominant bacterial species from the Berlin drinking water system. In: International Journal of Systematic Bacteriology, Band 49, Nr. 2, 1. April 1999, S. 769–777; doi:10.1099/00207713-49-2-769, PMID 10319501 (englisch).
- ↑ a b c LPSN: Genus Aquabacterium Kalmbach et al. 1999.
- ↑ Sung-Eun Lee, Qing Li, Jian Yu: Diverse protein regulations on PHA formation in Ralstonia eutropha on short chain organic acids. In: International Journal of Biological Sciences, Band 5, Nr. 3, Februar 2009, S. 215-225; doi:10.7150/ijbs.5.215, PMID 19270755, PMC 2651621 (freier Volltext), ResearchGate:24186153 (englisch). Siehe insbes. Fig. 2.
- ↑ Patent DE69233223T2: Herstellung von Polyalkanoat. Angemeldet am 15. Juli 1992, veröffentlicht am 26. August 2004, Anmelder: Metabolix Inc, Erfinder: Matthias Liebergesell, Alexander Steinbüchel.
- ↑ Comamonadaceae bacterium URHA0028 Taxon: Comamonadaceae, Synonyms: beta-1 subgroup (biocyc.org).
- ↑ a b c NCBI Taxonomy Browser: Aquabacterium, Details: Aquabacterium Kalmbach et al. 1999 emend. Chen et al. 2012 (genus).
- ↑ a b c GTDB: Aquabacterium (genus).
- ↑
Losee Lucy Ling, Tanja Schneider, Aaron J. Peoples, Amy L. Spoering, Ina Engels, Brian P. Conlon, Anna Mueller, Till F. Schäberle, Dallas E. Hughes, Slava Epstein, Michael Jones, Linos Lazarides, Victoria A. Steadman, Douglas R. Cohen, Cintia R. Felix, K. Ashley Fetterman, William P. Millett, Anthony G. Nitti, Ashley M. Zullo, Chao Chen, Kim Lewis: A new antibiotic kills pathogens without detectable resistance. In: Nature. 517. Jahrgang, Nr. 7535, 7. Januar 2015, S. 455–459, doi:10.1038/nature14098, PMID 25561178, PMC 7414797 (freier Volltext), bibcode:2015Natur.517..455L (englisch). Dazu:
- Extended Data Figure 2. 16S rRNA gene phylogeny of Eleftheria terrae.
- Erratum vom 16. April 2015; doi:10.1038/nature14303.
- ↑ Wen-Ming Chen, Nian-Tsz Cho, Shwu-Harn Yang, A. b. Arun, Chiu-Chung Young, Shih-Yi Sheu: Aquabacterium limnoticum sp. nov., isolated from a freshwater spring. In: International Journal of Systematic and Evolutionary Microbiology, Band 62, Nr. 3, März 2012, S. 698-704; doi:10.1099/ijs.0.030635-0, PMID 21551326, Epub 6. Mai 2011 (englisch).
- ↑ Aquabacterium sp. NJ1 Taxon: Aquabacterium, Rank: genus (biocyc.org).